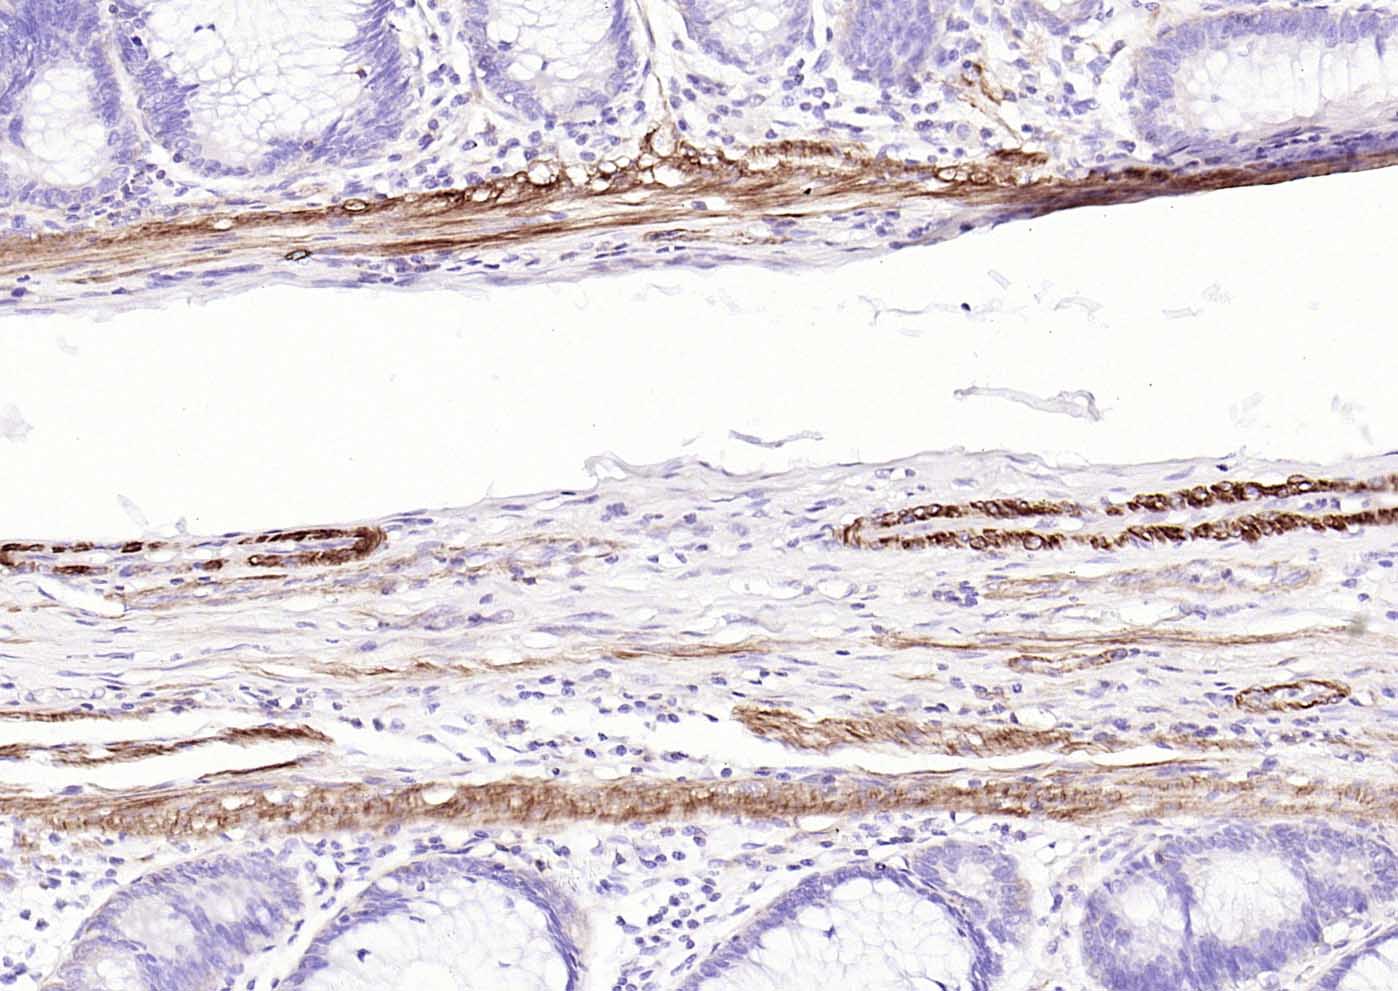
泛肌动蛋白重组兔单抗
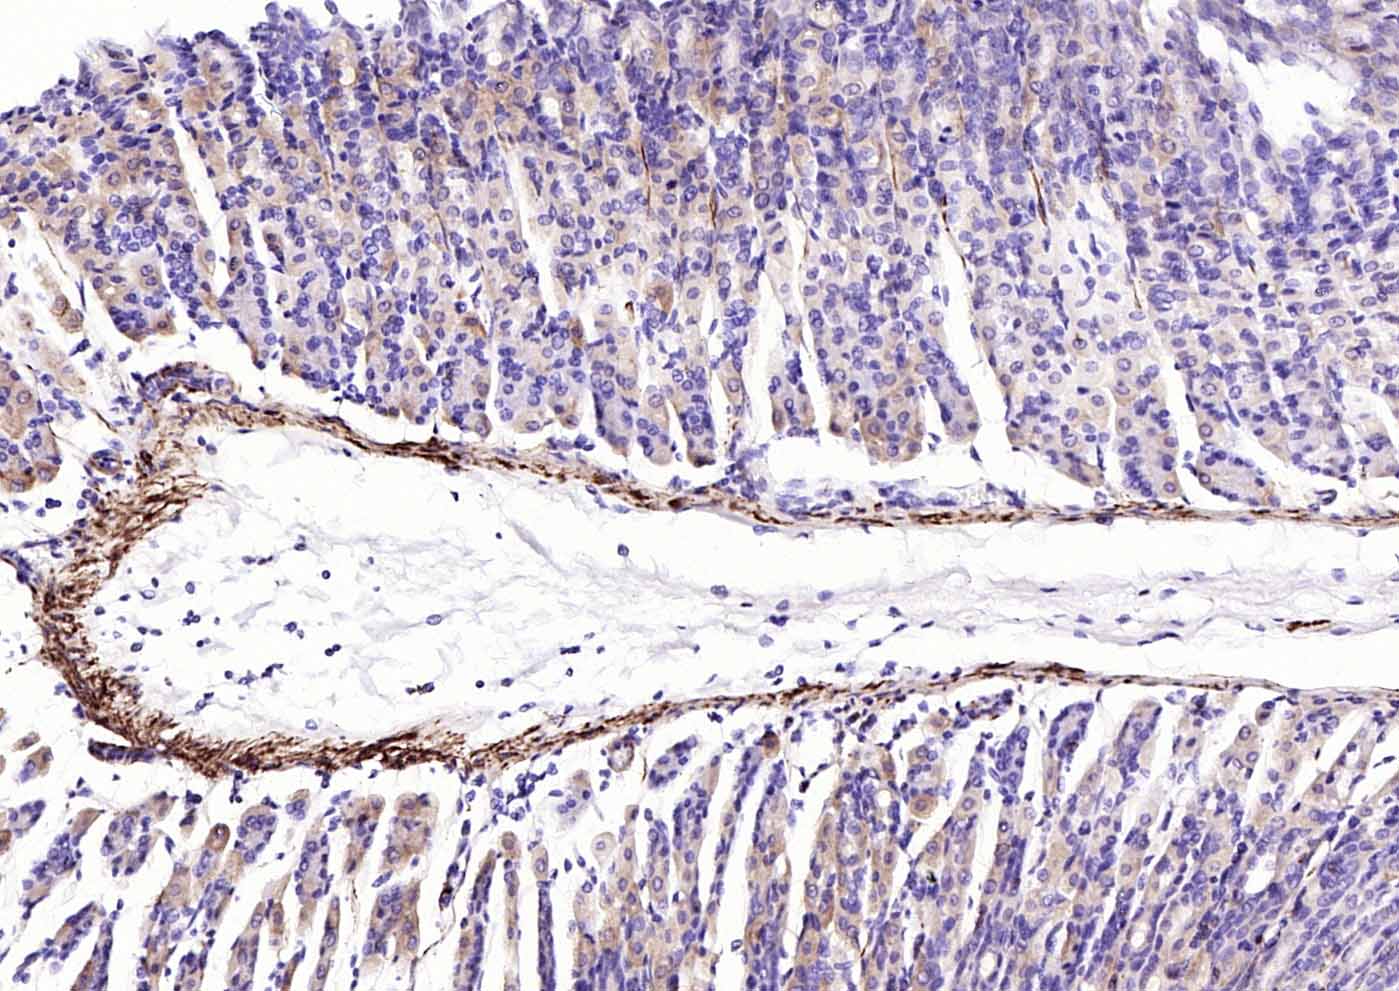
泛肌动蛋白重组兔单抗

Cardiovascular > Cardiovascular Markers > Cell Markers > Smooth Muscle Cells
Cardiovascular > Heart > Contractility > Contractile Proteins > Actins
Cardiovascular > Vasculature > Smooth muscle cell (SMC) > Cytoskeleton
Cardiovascular > Vasculature > Vasculature Markers > Arterial
Developmental Biology > Lineage specification > Mesoderm
Signal Transduction > Cytoskeleton / ECM > Cytoskeleton > Microfilaments > Actin etc > Actin
Actins are highly conserved proteins that are involved in various types of cell motility and are ubiquitously expressed in all eukaryotic cells.In vertebrates 3 main groups of actin isoforms, alpha, beta and gamma have been identified. The alpha actins are found in muscle tissues and are a major constituent of the contractile apparatus. The beta and gamma actins coexist in most cell types as components of the cytoskeleton and as mediators of internal cell motility. Actin proteins have very high homology.
The immunogen for this product is based on the ACTC1 protein but this antibody will also recognize: ACTB, ACTA1, ACTG1, ACTA2, ACTG2.

| 应用 | 已检合格种属 | 预测种属 | 推荐稀释比例 |
|---|---|---|---|
| WB | Human | Mouse, Rat | 1:500-1000 |
| IHC-P | Human, Mouse, Rat | 1:100-500 | |
| IHC-F | Human, Mouse, Rat | 1:100-500 | |
| IF | Human, Mouse, Rat | 1:100-500 | |
| Flow-Cyt | Human | Mouse, Rat | 1:50-100 |
| ICC/IF | Human, Mouse | Rat | 1:50-200 |
交叉反应: Human, Mouse, Rat
暂无相关产品
暂无标记数据
暂无同靶标产品
暂无相关文献
暂无常见问题